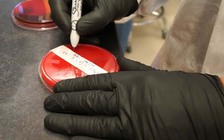
Vi khuẩn 'ác mộng' xuất hiện tại Mỹ

Tác giả
Lan Chi
Có thể bạn quan tâm

Tác giả
Đỗ Hồng Thương
Tác giả
Kiều Dương
Tác giả
Chim Gõ Kiến
Tác giả
Đặng Vỹ
Tác giả
Văn Sơn
Tác giả
An Nguyễn
Danh sách bài viết
(514 bài)
Tháng 06, 2016
Tháng 05, 2016